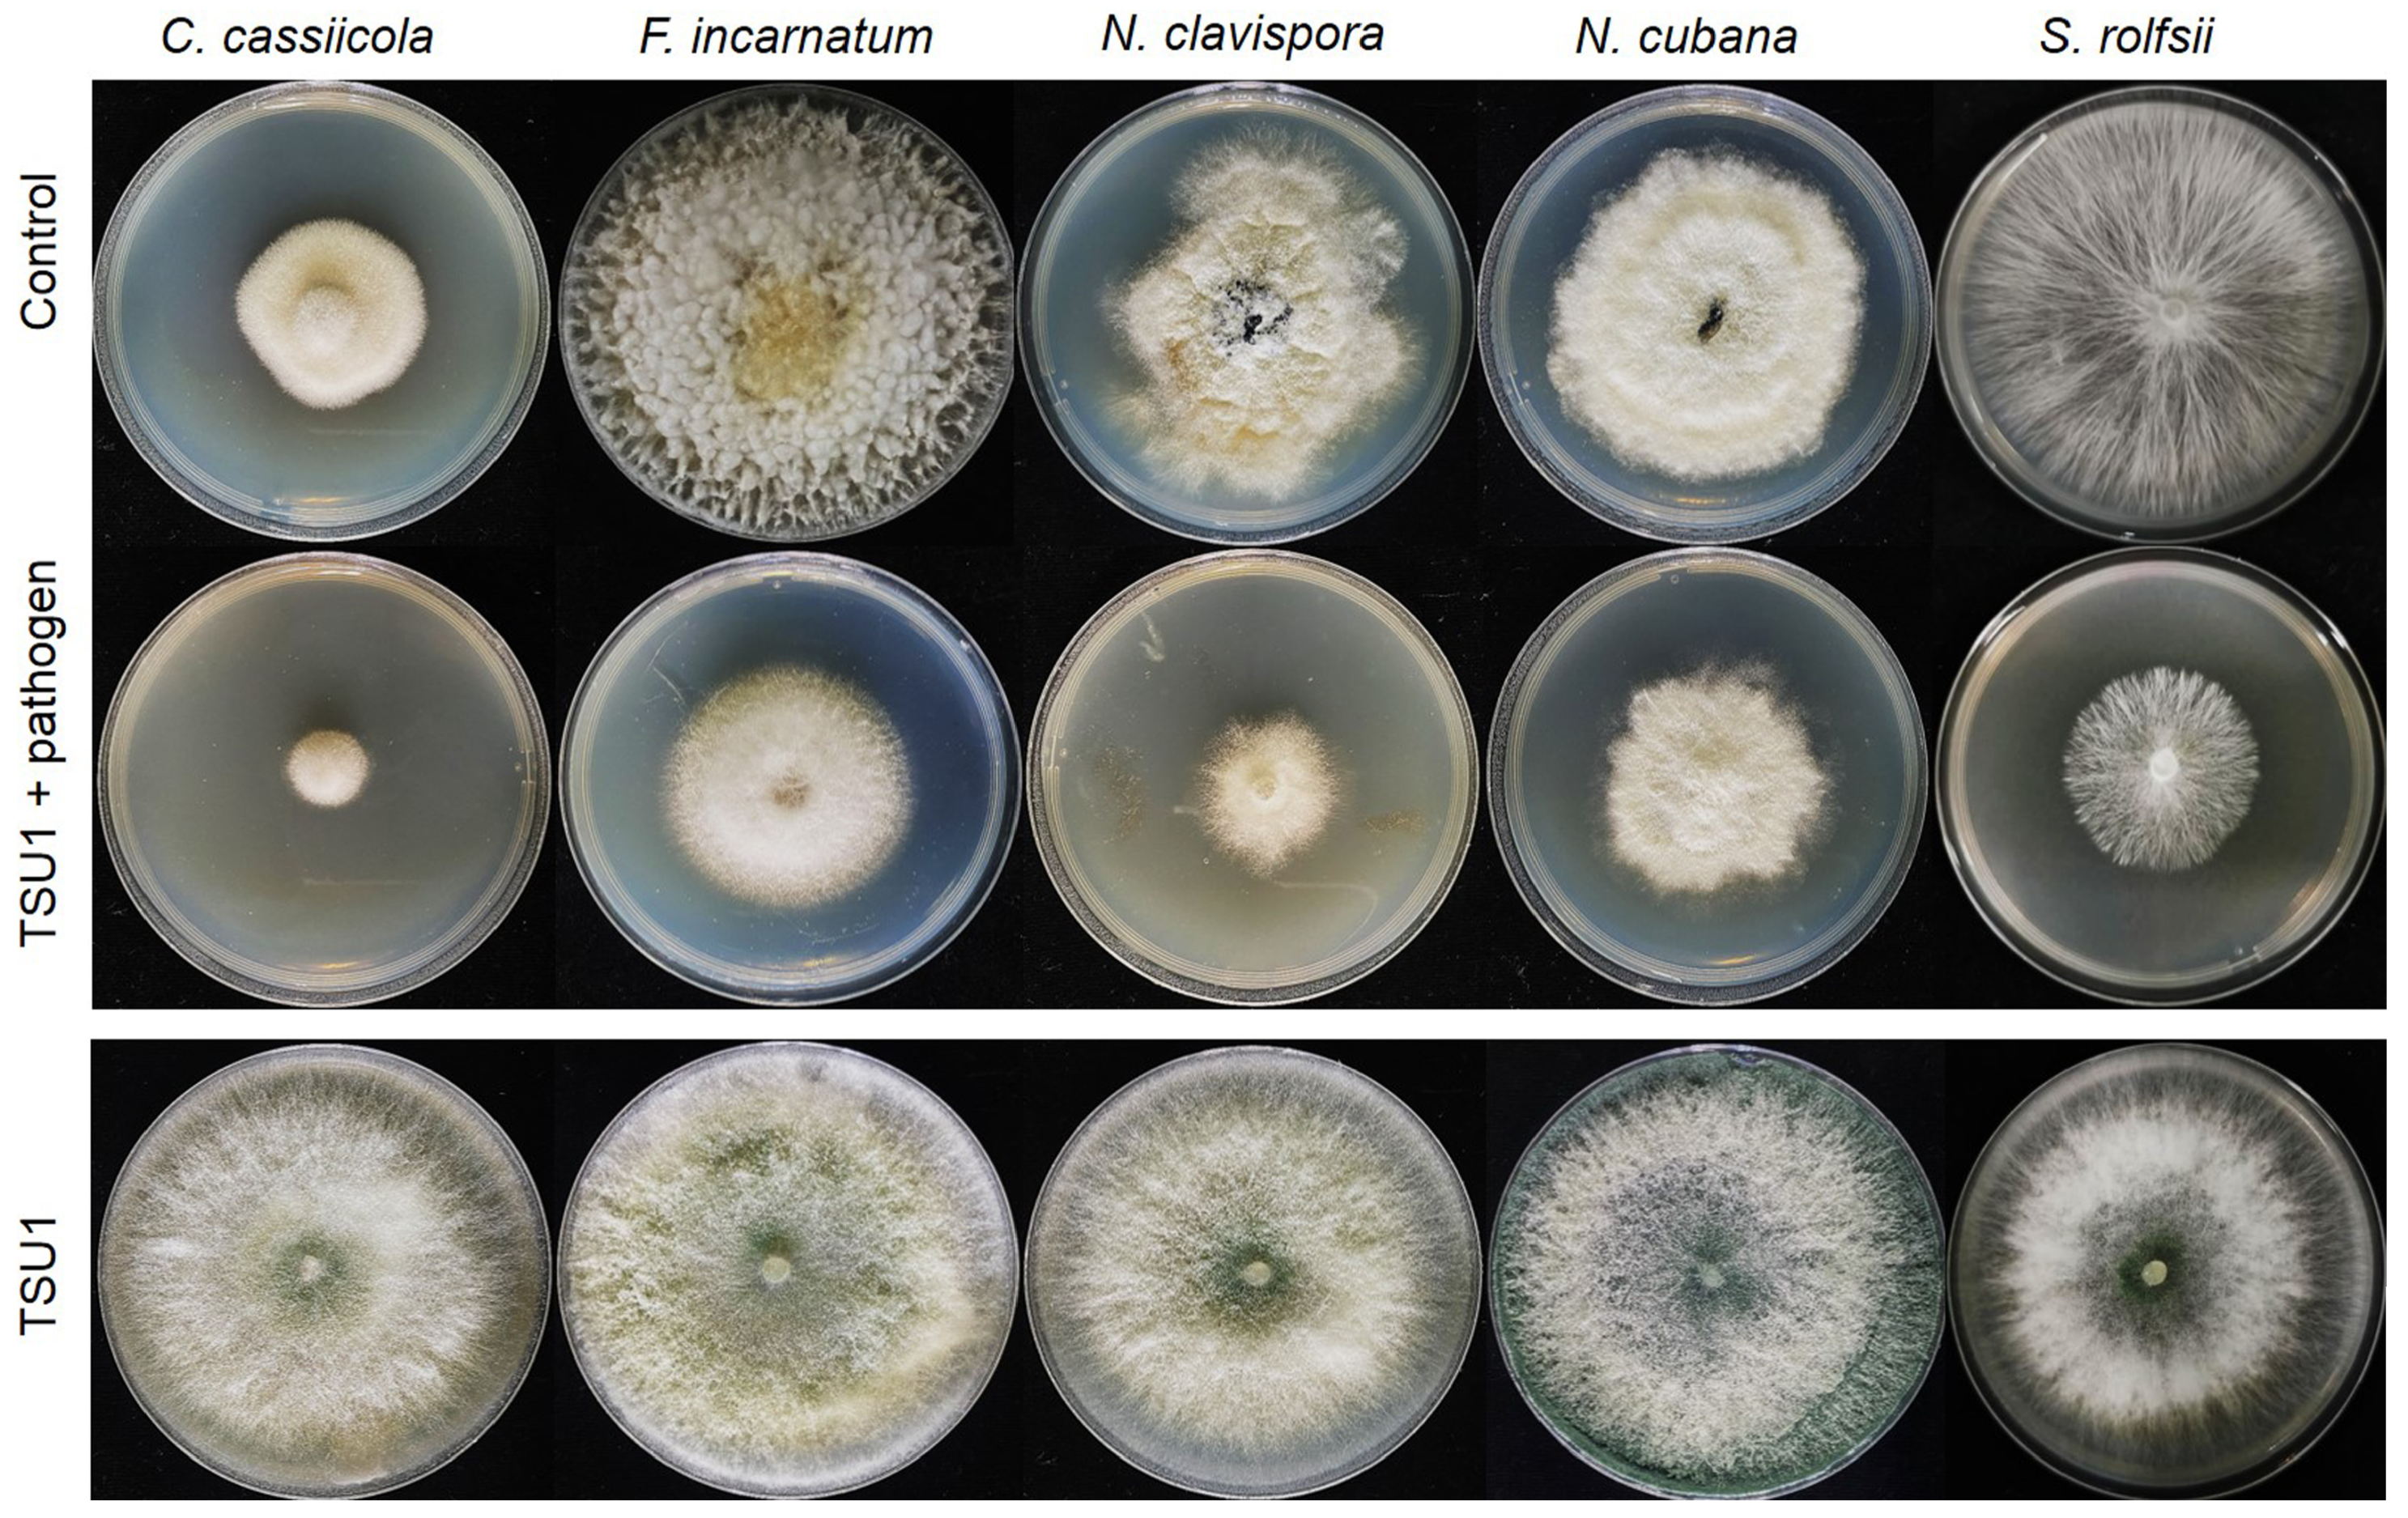
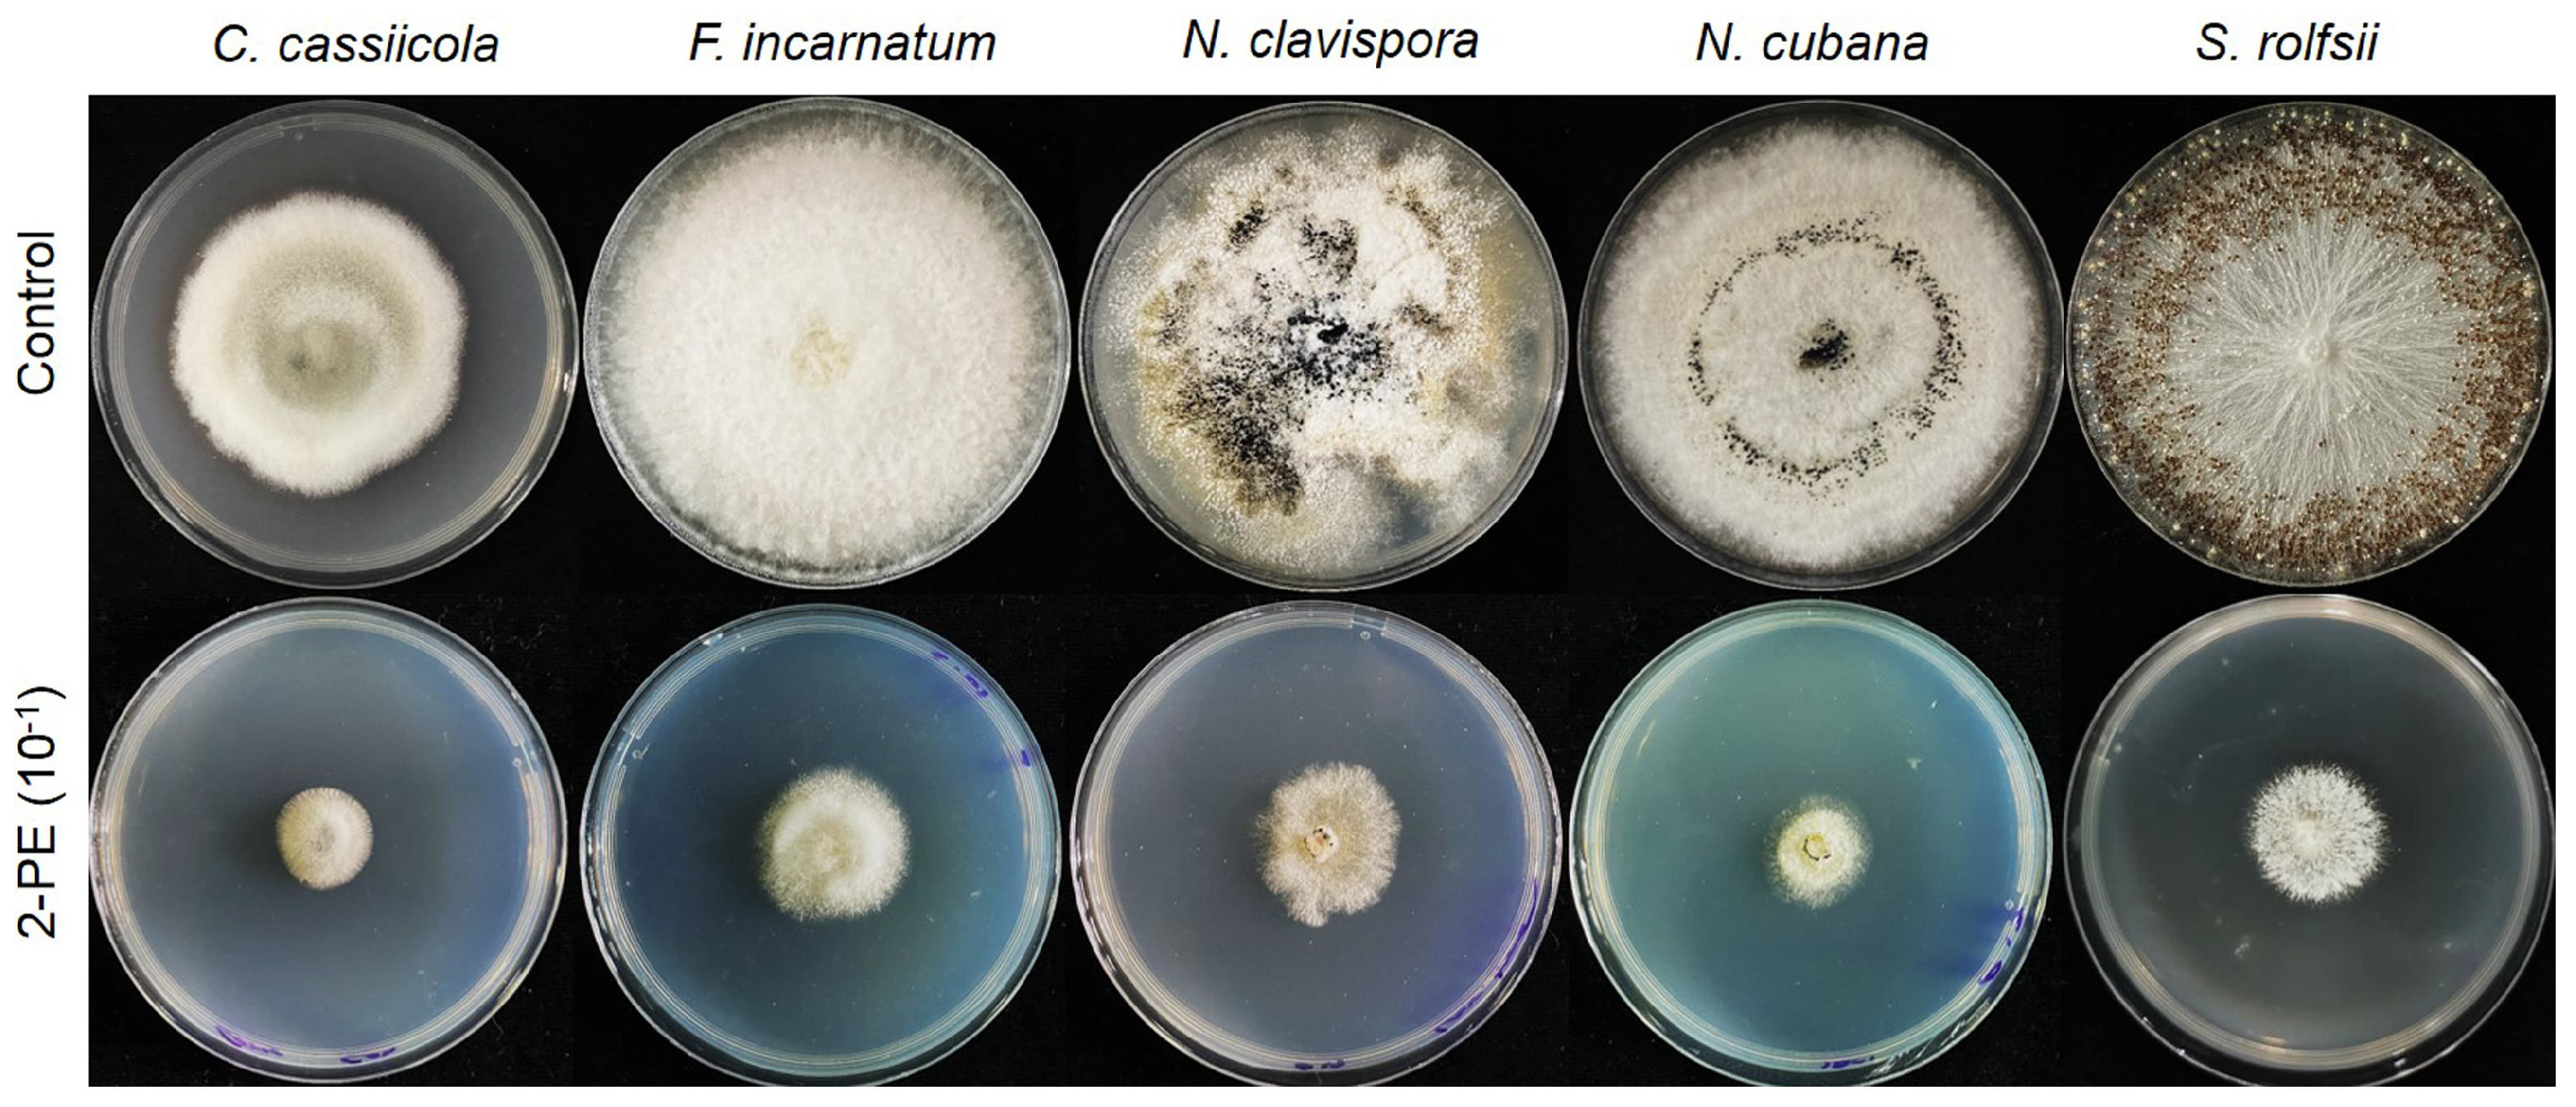

Volatile Organic Compound from Trichoderma asperelloides TSU1: Impact on Plant Pathogenic Fungi
Abstract
1. Introduction
2. Materials and Methods
2.1. Isolation and Morphological Identification
2.2. Pathogen Sources
2.3. Molecular Identification
2.4. Sealed Plate Method
2.5. SPME/GC/MS Analysis
2.6. Effect of Commercial Volatile Compounds on Fungal Growth
2.7. Statistical Analysis
3. Results
3.1. Taxonomy
3.2. Trichoderma asperelloides TSU1 Released VOCs against Fungal Pathogens
3.3. Identification of VOCs through SPME/GC/MS
3.4. Effect of 2-PE on Fungal Growth
4. Discussion
5. Conclusions
Author Contributions
Funding
Institutional Review Board Statement
Informed Consent Statement
Data Availability Statement
Acknowledgments
Conflicts of Interest
References
- Frąc, M.; Hannula, S.E.; Bełka, M.; Jędryczka, M. Fungal Biodiversity and Their Role in Soil Health. Front. Microbiol. 2018, 9, 707. [Google Scholar] [CrossRef]
- Frąc, M.; Weber, J.; Gryta, A.; Dębicka, M.; Kocowicz, A.; Jamroz, E.; Oszust, K.; Żołnierz, L. Microbial Functional Diversity in Podzol Ectohumus Horizons Affected by Alkaline Fly Ash in the Vicinity of Electric Power Plant. Geomicrobiol. J. 2017, 34, 579–586. [Google Scholar] [CrossRef]
- Etschmann, M.M.; Huth, I.; Walisko, R.; Schuster, J.; Krull, R.; Holtmann, D.; Wittmann, C.; Schrader, J. Improving 2-phenylethanol and 6-pentyl-α-pyrone production with fungi by microparticle-enhanced cultivation (MPEC). Yeast 2015, 32, 145–157. [Google Scholar] [CrossRef] [PubMed]
- Morán-Diez, M.E.; Trushina, N.; Lamdan, N.; Rosenfelder, L.; Mukherjee, P.K.; Kenerley, C.M.; Horwitz, B.A. Host-specific transcriptomic pattern of Trichoderma virens during interaction with maize or tomato roots. BMC Genom. 2015, 16, 8. [Google Scholar] [CrossRef]
- Oskiera, M.; Szczech, M.; Stępowska, A.; Smolińska, U.; Bartoszewski, G. Monitoring of Trichoderma species in agricultural soil in response to application of biopreparations. Biol. Control 2017, 113, 65–72. [Google Scholar] [CrossRef]
- Amira, R.D.; Roshanida, A.R.; Rosli, M.I.; Zahrah, M.S.F.; Anuar, J.M.; Adha, C.N. Bio-conversion of empty fruit bunches (EFB) and palm oil mill effluent (POME) into compost using Trichoderma virens. Afr. J. Biotechnol. 2011, 10, 18775–18780. [Google Scholar]
- Hyakumachi, M.; Kubota, M. Fungi as Plant Growth Promoter and Disease Suppressor. In Fungal Biotechnology in Agricultural, Food and Environmental Application; Arora, D.K., Ed.; Marcel Dekker: New York, NY, USA, 2003; pp. 101–110. [Google Scholar]
- Woo, S.L.; Ruocco, M.; Vinale, F.; Nigro, M.; Marra, R.; Lombardi, N.; Pascale, A.; Lanzuise, S.; Manganiello, G.; Lorito, M. Trichoderma-based Products and their Widespread Use in Agriculture. Open Mycol. J. 2014, 8, 71–126. [Google Scholar] [CrossRef]
- Sunpapao, A. Antagonistic Microorganisms: Current Research and Innovations; Lambert Academic Publishing: Saarbrucken, Germany, 2020; p. 120. [Google Scholar]
- Ahlawat, O.P.; Gupta, P.; Kumar, S.; Sharma, D.K. Bioremediation of fungicides by spent mushroom substrate and its associ-ated microflora. Indian J. Microbiol. 2010, 50, 390–395. [Google Scholar] [CrossRef]
- Sunpapao, A.; Chairin, T.; Ito, S. The biocontrol by Streptomyces and Trichoderma of leaf spot disease caused by Curvularia oryzae in oil palm seedlings. Biol. Control 2018, 123, 36–42. [Google Scholar] [CrossRef]
- Baiyee, B.; Pornsuriya, C.; Ito, S.; Sunpapao, A. Trichoderma spirale T76-1 displays biocontrol activity against leaf spot on lettuce (Lactuca sativa L.) caused by Corynespora cassiicola or Curvularia aeria. Biol. Control 2019, 129, 195–200. [Google Scholar] [CrossRef]
- Bailey, B.A.; Bae, H.; Strem, M.D.; Crozier, J.; Thomas, S.E.; Samuels, G.J.; Vinyard, B.T.; Holmes, K.A. Antibiosis, mycoparasitism, and colonization success for endophytic Trichoderma isolates with biological control potential in Theobroma cacao. Biol. Control 2008, 46, 24–35. [Google Scholar] [CrossRef]
- John, R.P.; Tyagi, R.D.; Prévost, D.; Brar, S.K.; Pouleur, S.; Surampalli, R.Y. Mycoparasitic Trichoderma viride as a biocontrol agent against Fusarium oxysporum f. sp. adzuki and Pythium arrhenomanes and as a growth promoter of soybean. Crop. Prot. 2010, 29, 1452–1459. [Google Scholar] [CrossRef]
- Wonglom, P.; Ito, S.; Sunpapao, A. Volatile organic compounds emitted from endophytic fungus Trichoderma asperellum T1 mediate antifungal activity, defense response and promote plant growth in lettuce (Lactuca sativa). Fungal Ecol. 2020, 43, 100867. [Google Scholar] [CrossRef]
- Phoka, N.; Suwannarach, N.; Lumyong, S.; Ito, S.-I.; Matsui, K.; Arikit, S.; Sunpapao, A. Role of volatiles from the endophyt-ic fungus Trichoderma asperelloides PSU-P1 in biocontrol potential and in promoting the plant growth of Arabidopsis thaliana. J. Fungi 2020, 6, 341. [Google Scholar] [CrossRef]
- Aamir, M.; Kashyap, S.P.; Zehra, A.; Dubey, M.K.; Singh, V.K.; Ansari, W.A.; Upadhyay, R.S.; Singh, S. Trichoderma erinaceum bio-priming modulates the WRKYs defense programming in tomato against the Fusarium oxysporum f. sp. lycopersici (Fol) challenged condition. Front. Plant Sci. 2019, 10, 911. [Google Scholar] [CrossRef]
- Baiyee, B.; Ito, S.; Sunpapao, A. Trichoderma asperellum T1 mediated antifungal activity and induced defense response against leaf spot fungi in lettuce (Lactuca sativa L.). Physiol. Mol. Plant Pathol. 2019, 106, 96–101. [Google Scholar] [CrossRef]
- Halifu, S.; Deng, X.; Song, X.; Song, R. Effects of Two Trichoderma Strains on Plant Growth, Rhizosphere Soil Nutrients, and Fungal Community of Pinus sylvestris var. mongolica Annual Seedlings. Forest 2019, 10, 758. [Google Scholar] [CrossRef]
- Benıtez, T.; Rinc’on, A.M.; Lim´on, M.C.; Codón, A.C. Biocontrol mechanisms of Trichoderma strains. Int. Microbiol. 2004, 7, 249–260. [Google Scholar]
- Harman, G.E. Overview of Mechanisms and Uses of Trichoderma spp. Phytopathology 2006, 96, 190–194. [Google Scholar] [CrossRef] [PubMed]
- Elsherbiny, E.A.; Amin, B.H.; Aleem, B.; Kingsley, K.L.; Bennet, J.W. Trichoderma volatile organic compounds as a biofumi-gant tool against late blight pathogen Phytophthora infestans in postharvest potato tubers. J. Agric. Food Chem. 2020, 68, 8163–8171. [Google Scholar] [CrossRef] [PubMed]
- Intana, W.; Kheawleng, S.; Sunpapao, A. Trichoderma asperellum T76-14 Released Volatile Organic Compounds against Post-harvest Fruit Rot in Muskmelons (Cucumis melo) Caused by Fusarium incarnatum. J. Fungi 2021, 7, 46. [Google Scholar] [CrossRef]
- Wonglom, P.; Daengsuwan, W.; Ito, S.; Sunpapao, A. Biological control of Sclerotium fruit rot of snake fruit and stem rot of lettuce by Trichoderma sp. T76-12/2 and the mechanisms involved. Physiol. Mol. Plant Pathol. 2019, 107, 1–7. [Google Scholar] [CrossRef]
- Chairin, T.; Pornsuriya, C.; Thaochan, N.; Sunpapao, A. Corynespora cassiicola causes leaf spot disease on lettuce (Lactuca sativa) cultivated in hydroponic systems in Thailand. Australas. Plant Dis. Notes 2017, 12, 1–3. [Google Scholar] [CrossRef]
- Daengsuwan, W.; Wonglom, P.; Arikit, S.; Sunpapao, A. Morphological and molecular identification of the Neopestalotiopsis clavispora associated with flower blight on Anthurium andraeanum in Thailand. Hort. Plant J. 2021. accepted. [Google Scholar]
- Pornsuriya, C.; Chairin, T.; Thaochan, N.; Sunpapao, A. Identification and characterization of Neopestalotiopsis fungi associated with a novel leaf fall disease of rubber trees (Hevea brasiliensis) in Thailand. J. Phytopath. 2020, 168, 416–427. [Google Scholar] [CrossRef]
- Wonglom, P.; Sunpapao, A. Fusarium incarnatum is associated with postharvest fruit rot of muskmelon (Cucumis melo). J. Phytopathol. 2020, 168, 204–210. [Google Scholar] [CrossRef]
- White, T.J.; Bruns, T.; Lee, S.; Tayler, J. Amplification and direct Sequencing of Fungal Ribosomal RNA Genes for Phylogenies. In PCR Protocols: A Guide to Methods and Applications; Innis, A.M., Gelfelfard, D.H., Snindky, J.J., White, T.J., Eds.; Academic Press: San Diego, CA, USA, 1990; pp. 315–322. [Google Scholar]
- Liu, Y.J.; Whelen, S.; Hall, B.D. Phylogenetic relationships among ascomycetes: Evidence from an RNA polymerase II subunit. Molec. Biol. Evol. 1999, 16, 1799–1808. [Google Scholar] [CrossRef]
- Carbone, I.; Kohn, L.M. A method for designing primer sets for speciation studies in filamentous ascomycetes. Mycologia 1999, 91, 553–556. [Google Scholar] [CrossRef]
- Samuels, G.J.; Isaiel, A.; Bon, M.-C.; De Respinis, S.; Petrini, O. Trichoderma asperellum sensu lato consists of two cryptic spe-cies. Mycologia 2010, 102, 944–966. [Google Scholar] [CrossRef]
- Edgar, R.C. MUSCLE: Multiple sequence alignment with high accuracy and high throughput. Nucleic Acids Res. 2004, 32, 1792–1797. [Google Scholar] [CrossRef]
- Darriba, D.; Taboada, G.L.; Doallo, R.; Posada, D. jModelTest 2: More models, new heuristics and parallel computing. Nat. Methods 2012, 9, 772. [Google Scholar] [CrossRef]
- Felsenstein, J. Confidence intervals on phylogenetics: An approach using bootstrap. Evolution 1985, 39, 783–791. [Google Scholar] [CrossRef]
- Stamatakis, A. RAxML-VI-HPC: Maximum likelihood-based phylogenetic analyses with thousands of taxa and mixed mod-els. Bioinformatics 2006, 22, 2688–2690. [Google Scholar] [CrossRef] [PubMed]
- Ronquist, F.; Klopfstein, S.; Vilhelmsen, L.; Schulmeister, S.; Murray, D.L.; Rasnitsyn, A.P. A total-evidence approach to dating with fossils, applied to the early radiation of the Hymenoptera. Syst. Biol. 2012, 61, 973–999. [Google Scholar] [CrossRef] [PubMed]
- Hillis, D.M.; Bull, J.J. An empirical test of bootstrapping as a method for assessing confidence in phylogenetic analysis. Syst. Biol. 1993, 42, 182–192. [Google Scholar] [CrossRef]
- Alfaro, M.E.; Zoller, S.; Lutzoni, F. Bayes or Bootstrap? A Simulation Study Comparing the Performance of Bayesian Markov Chain Monte Carlo Sampling and Bootstrapping in Assessing Phylogenetic Confidence. Mol. Biol. Evol. 2003, 20, 255–266. [Google Scholar] [CrossRef] [PubMed]
- Dennis, C.; Webster, J. Antagonistic properties of species-groups of Trichoderma, II. Production of volatile antibiotic. Trans. Br. Mycol. Soc. 1971, 57, 41–48. [Google Scholar] [CrossRef]
- Jang, S.; Jang, Y.; Kim, C.-W.; Lee, H.; Hong, J.-H.; Heo, Y.M.; Lee, Y.M.; Lee, D.W.; Lee, H.B.; Kim, J.-J. Five New Records of Soil-Derived Trichoderma in Korea: T. albolutescens, T. asperelloides, T. orientale, T. spirale, and T. tomentosum. Mycobiology 2017, 45, 1–8. [Google Scholar] [CrossRef][Green Version]
- Chen, K.; Zhuang, W.-Y. Trichoderma shennongjianum and Trichoderma tibetense, two new soil-inhabiting species in the Strictipile clade. Mycoscience 2016, 57, 311–319. [Google Scholar] [CrossRef]
- Qiao, M.; Du, X.; Zhang, Z.; Xu, J.; Yu, Z. Three new species of soil-inhabiting Trichoderma from southwest China. MycoKeys 2018, 44, 63–80. [Google Scholar] [CrossRef]
- Medina-Romero, Y.M.; Roque-Flores, G.; Macías-Rubalcava, M.L. Volatile organic compounds from endophytic fungi as innovative postharvest control of Fusarium oxysporum in cherry tomato fruits. Appl. Microbiol. Biotechnol. 2017, 101, 8209–8222. [Google Scholar] [CrossRef] [PubMed]
- Liu, P.; Cheng, Y.; Yang, M.; Liu, Y.; Chen, K.; Long, C.; Deng, X. Mechanisms of action for 2-phenylethylethanol isolated from Kloeckera apiculata in control of Penicillium molds of citrus fruits. BMC Microbiol. 2014, 14, 242. [Google Scholar] [CrossRef] [PubMed]

| Pathogen | Disease | Host | Sources |
|---|---|---|---|
| Corynespora cassiicola | Leaf spot | Lactuca sativa | [25] |
| Fusarium incarnatum | Fruit rot | Cucumis melo | [28] |
| Neopestalotiopsis clavispora | Flower blight | Anthurium andraeanum | [26] |
| N. cubana | Leaf fall | Hevea brasiliensis | [27] |
| Sclerotium rolfsii | Stem rot | Helianthus tuberosus | CCPM * |
| Region | Primer | Orientation | Annealing Temperature (°C) | Reference |
|---|---|---|---|---|
| ITS * | ITS5 | Forward | 50 | [29] |
| ITS4 | Reverse | 50 | [29] | |
| rpb2 | fRPB2-5F | Forward | 54 | [30] |
| fRPB2-7cr | Reverse | 54 | [30] | |
| tef1-α | Tef1-728F | Forward | 52 | [31] |
| Tef1-986R | Reverse | 52 | [32] |
| Retention Time | IUPAC Name | Formula | Percentage Match (%) | Percentage Area (%) |
|---|---|---|---|---|
| 1.575 | Fluoro(trinitro)methane | CFN3O6 | 95 | 18.192 |
| 2.309 | Azetidine | C3H7N | 87.1 | 2.628 |
| 5.303 | 1-Methyl-2-propan-2-ylbenzene | C10H14 | 81.9 | 0.675 |
| 5.656 | 3,7-Dimethylundecane | C13H28 | 82.2 | 2.182 |
| 6.287 | 5,7-Dimethylundecane | C13H28 | 84.4 | 2.215 |
| 6.464 | 4-Methyl-2-(2-methylprop-1-enyl)oxane | C10H18O | 85.1 | 5.639 |
| 6.514 | 2-Phenylethanol | C8H10O | 92.1 | 9.803 |
| 6.712 | (2R,4R)-4-Methyl-2-(2-methylprop-1-enyl)oxane | C10H18O | 91.6 | 2.296 |
| 7.453 | (2,2-Dimethylcyclopentyl)cyclohexane | C13H24 | 68.6 | 1.989 |
| 8.201 | 1,3-Benzothiazole | C7H5NS | 82.3 | 1.506 |
| 11.639 | 1-Methyl-4-(6-methylhept-5-en-2-yl)cyclohexa-1,4-diene | C15H24 | 82 | 4.386 |
| 11.831 | 7,11-Dimethyl-3-methylidenedodeca-1,6,10-triene | C15H24 | 76.1 | 0.811 |
| 13.297 | 4,7-Dimethyl-1-propan-2-yl-2,3,4,5,6,8a-hexahydro-1H-naphthalen-4a-ol | C15H26O | 74.3 | 0.701 |
| 14.033 | Cyclohexylmethyl hexyl sulfite | C13H26O3S | 77.8 | 1.418 |
| 14.578 | Methyl icosa-11,14-dienoate | C21H38O2 | 82.5 | 3.708 |
| 14.804 | Ethyl (E)-octadec-9-enoate | C20H38O2 | 82.5 | 5.449 |
| 16.998 | Ethyl hexadecanoate | C18H36O2 | 84.4 | 6.003 |
Publisher’s Note: MDPI stays neutral with regard to jurisdictional claims in published maps and institutional affiliations. |
© 2021 by the authors. Licensee MDPI, Basel, Switzerland. This article is an open access article distributed under the terms and conditions of the Creative Commons Attribution (CC BY) license (http://creativecommons.org/licenses/by/4.0/).
Share and Cite
Ruangwong, O.-U.; Wonglom, P.; Suwannarach, N.; Kumla, J.; Thaochan, N.; Chomnunti, P.; Pitija, K.; Sunpapao, A. Volatile Organic Compound from Trichoderma asperelloides TSU1: Impact on Plant Pathogenic Fungi. J. Fungi 2021, 7, 187. https://doi.org/10.3390/jof7030187
Ruangwong O-U, Wonglom P, Suwannarach N, Kumla J, Thaochan N, Chomnunti P, Pitija K, Sunpapao A. Volatile Organic Compound from Trichoderma asperelloides TSU1: Impact on Plant Pathogenic Fungi. Journal of Fungi. 2021; 7(3):187. https://doi.org/10.3390/jof7030187
Chicago/Turabian StyleRuangwong, On-Uma, Prisana Wonglom, Nakarin Suwannarach, Jaturong Kumla, Narit Thaochan, Putarak Chomnunti, Kitsada Pitija, and Anurag Sunpapao. 2021. "Volatile Organic Compound from Trichoderma asperelloides TSU1: Impact on Plant Pathogenic Fungi" Journal of Fungi 7, no. 3: 187. https://doi.org/10.3390/jof7030187
APA StyleRuangwong, O.-U., Wonglom, P., Suwannarach, N., Kumla, J., Thaochan, N., Chomnunti, P., Pitija, K., & Sunpapao, A. (2021). Volatile Organic Compound from Trichoderma asperelloides TSU1: Impact on Plant Pathogenic Fungi. Journal of Fungi, 7(3), 187. https://doi.org/10.3390/jof7030187

